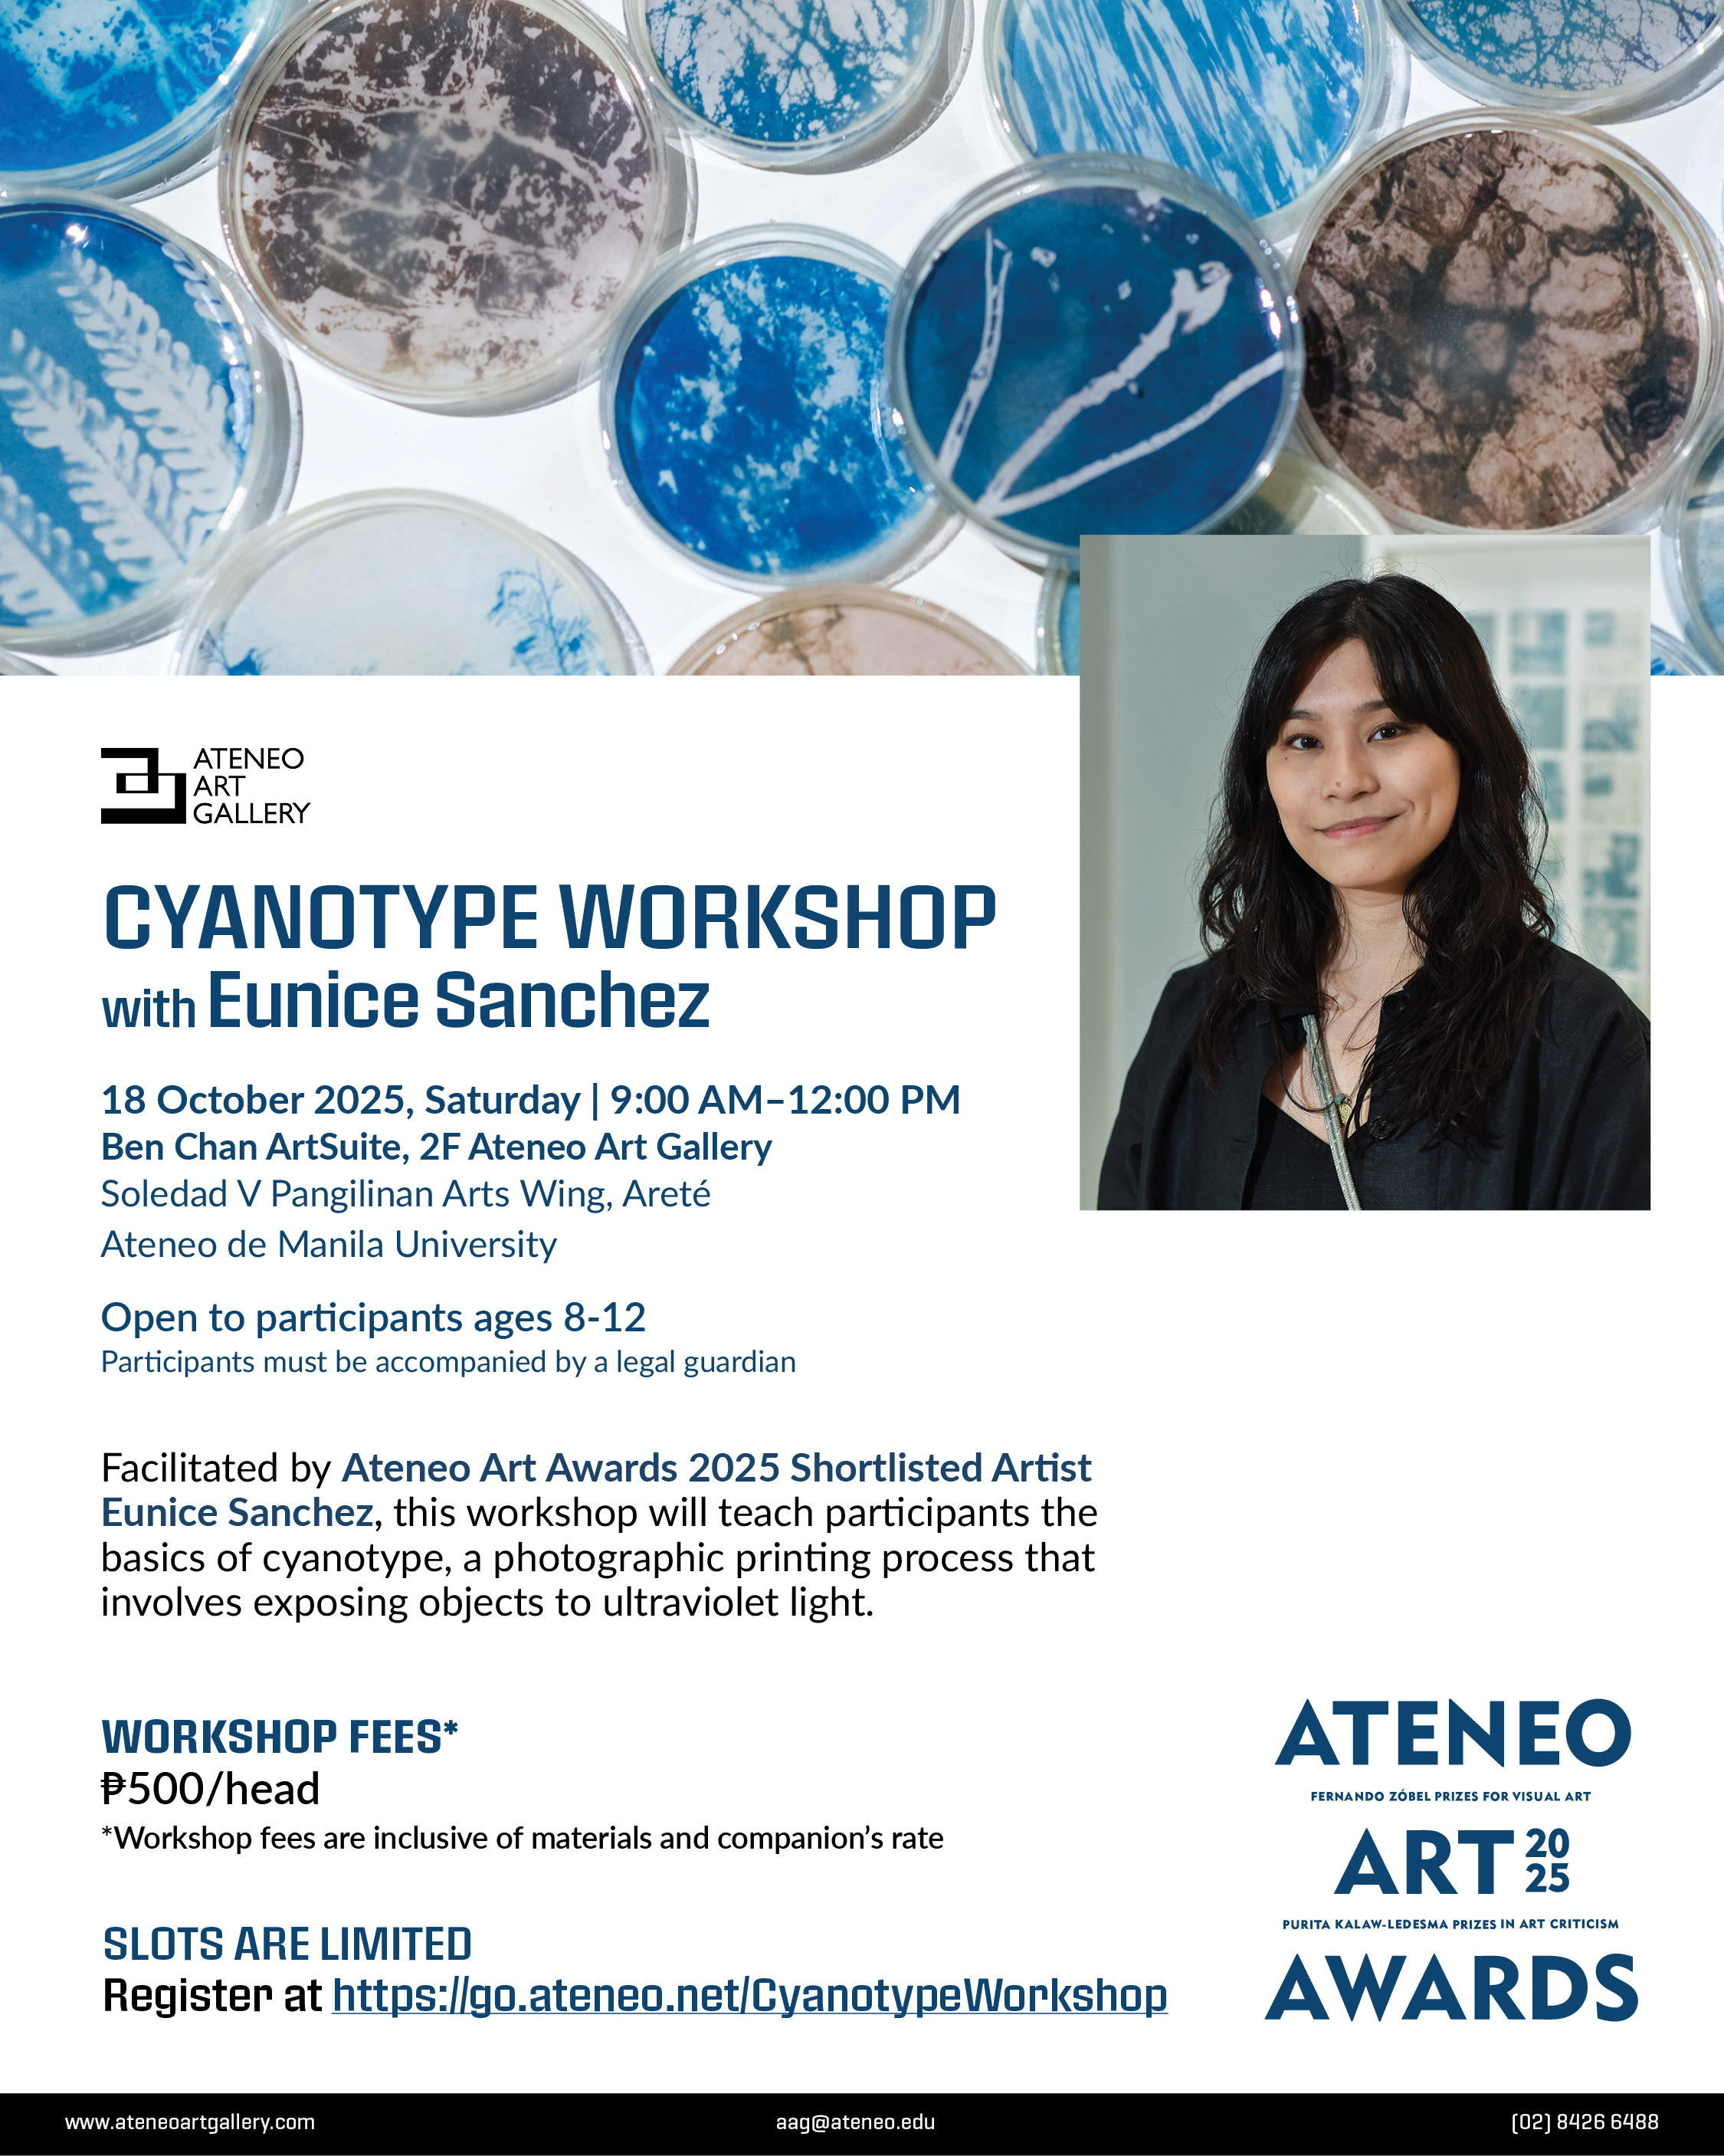
Cyanotype Workshop with Eunice Sanchez Poster

Workshop / Seminar / Short Course
Cyanotype Workshop with Ateneo Art Awards 2025 Shortlisted Artist Eunice Sanchez
Join the Ateneo Art Gallery for a cyanotype workshop facilitated by #AteneoArtAwards2025 Shortlisted Artist Eunice Sanchez! This workshop is open to kids ages 8–12 years old (must be accompanied by a legal guardian). The session will teach participants the basics of cyanotype, a photographic printing process that involves exposing objects to ultraviolet light.
18 October 2025, Saturday | 9:00 AM–12:00 PM
Ben Chan ArtSuite, 2F Ateneo Art Gallery
Soledad V Pangilinan Arts Wing, Areté
Ateneo de Manila University
Workshop fee*: Php 500/head
*Inclusive of materials and companion’s rate
REGISTER AT https://go.ateneo.net/CyanotypeWorkshop
ABOUT THE ARTIST
Eunice Sanchez utilizes photography and alternative photographic methods to explore preservation, perception, and the act of remembering. Her practice often touches on memory-keeping and storytelling, incorporating textile, installation, painting, and video in her works.
For inquiries, email aag@ateneo.edu or call (2) 8426 6488.
Latest Events
Retreat / Recollection
2026 Alumni Holy Week Triduum Retreat: Holy Week Triduum Reflections
Thu, 02 Apr 2026
Lecture / Talk / Discussion
The Cybercrime Wave in the Philippines: Institutionalizing Digital Forensics Toward Risk Management and Corporate Resilience
Wed, 08 Apr 2026
Lecture / Talk / Discussion
Imagining the Roads Ahead: Futures Thinking in Sustainable Development
Fri, 10 Apr 2026
Lecture / Talk / Discussion
Ateneo Intellectual Property Week 2026: IP and Sports – Ready, Set, Innovate!
Mon, 13 Apr 2026
